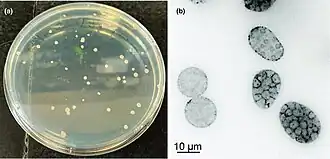

Spizellomyces punctatus
| Spizellomyces punctatus | ||||||||||||
|---|---|---|---|---|---|---|---|---|---|---|---|---|
Spizellomyces punctatus | ||||||||||||
| Systematik | ||||||||||||
| ||||||||||||
| Wissenschaftlicher Name | ||||||||||||
| Spizellomyces punctatus | ||||||||||||
| (W.J. Koch) D.J.S. Barr[1][2] |
Spizellomyces punctatus ist ein im Boden lebender Pilz aus der Gruppe der Chytridpilze (Chytridiomycetes).[3] Es handelt sich um einen saprotrophen Pilz, der sich in verrottendem Pflanzenmaterial ansiedelt.[4] Da S. punctatus im Stammbaum der Pilze ein früh divergierender (d. h. relativ basal stehender) Vertreter ist, hat er von seinen Vorfahren zelluläre Merkmale – wie sie typischerweise bei Amöben und Tieren (Metazoen) vorkommen – beibehalten.[5] Seine pathogenen Verwandten, Batrachochytrium dendrobatidis und B. salamandrivorans, infizieren Amphibien und verursachen einen weltweiten Verlust der biologischen Vielfalt.[6] Die Reinkultur von S. punctatus wurde erstmals 1957 von William J. Koch (unter dem Namen Phlyctochytrium punctatum) gewonnen.[7][1]
Der Pilz ist ein Modellorganismus.[5]
Genom
Das Genom des Stammes DAOM BR117 von S. punctatus wurde im Rahmen des Projekts Origins of Multicellularity sequenziert.[8] Seine Genomgröße beträgt etwa 24,13 Mbp (Megabasenpaare), der GC-Gehalt liegt bei 47,6 %. Das Genom enthält 9.424 vorhergesagte Transkripte und 8.952 vorhergesagte Protein-kodierende Gene. Die DDBJ/EMBL/GenBank-Zugangsnummer lautet ACOE00000000.[3][9]
Genetische Transformation
Die Transformation meint die nicht-virale Übertragung von DNA in kompetente (aufnahmebereite) Empfängerorganismen (hier: Pilze).
Agrobacterium-vermittelte Transformation
Die genetische Transformation von Zoosporen von S. punctatus durch den pflanzenpathogenen Stamm Agrobacterium tumefaciens EHA105 ist erfolgreich etabliert. Es wurden mehrere Selektionsmarker getestet. Das Wachstum von S. punctatus wird durch Geneticin (G418), Puromycin und Zeocin bis zu 800 mg/L nicht gehemmt. 200 mg/ℓ Hygromycin und 800 mg/ℓ Nourseothricin[10] (CloNAT) hemmen das Wachstum von S. punctatus dagegen vollständig. Die Autoren, von denen dieses Protokoll entwickelt wurde, verwendeten Hygromycin als Selektionsmarker. Die HSP70- und H2B-Promotoren von S. punctatus steuern eine ausreichende Genexpression für die in Backhefe (Saccharomyces cerevisiae) getestete Hygromycin-Resistenz und Expression des grün fluoreszierenden Proteins GFP. Unter der Kontrolle eines stärkeren H2B-Promotors kann GFP in S. punctatus jedoch nicht erfolgreich gefaltet werden. Unter den anderen bekannten fluoreszierenden Proteinen sind tdTomato,[11] mClover3,[12] mCitrine[13] und mCerulean3[14] S. punctatus funktionsfähig.[5]
Elektroporation
Ein hocheffizientes Elektroporationsprotokoll für S. punctatus und die beiden verwandten pathogenen Chytridenarten, Batrachochytrium dendrobatidis und B. salamandrivorans, wurde ebenfalls erstellt. Die optimale Spannung für S. punctatus beträgt 1000 V. Die Effizienz liegt bei etwa 95 %, wenn synchronisierte[15] Zoosporen verwendet werden. Die Elektroporation mit unsynchronisierten Zoosporen kann ebenfalls mehr als 80 % Effizienz erreichen.[16]
Lebenszyklus
Den kugelförmigen Zoosporen (Durchmesser 3–5 mm) von S. punctatus fehlt eine Zellwand. Die Zoosporen können mit einer beweglichen Zilie (Länge 20–24 mm) schwimmen oder mit Pseudopodien (Scheinfüßchen), die Aktin enthalten, auf Oberflächen kriechen.[5]
Während der Zystenbildung wird die Zilie zunächst durch die Internalisierung des Axonems abgebaut. Die Initiierung dieses Prozesses ist aktinabhängig. Das Axonem bleibt während der Internalisierung intakt und das axonemale (Axonem-eigene) Tubulin wird zumindest teilweise durch das Proteasom abgebaut. Die Zellwand wird nach der Internalisierung des Axonems gebildet. Bei S. punctatus gibt es fünf Arten (Modi) der Axonem-Internalisierung: Abtrennung, Einziehen (Retraktion), Umschlingung, Verlust des Ziliarkompartiments und vesikuläre Retraktion.[A. 1][17][18]
- Die erste Form der Abtrennung wird als Zilienablösung bezeichnet.
- Bei der zweiten wird die Retraktion mit oder ohne kortikale Rotation durchgeführt und als Body-Twist-Retraktion bzw. Straight-In-Retraktion bezeichnet.
- Beim dritten Modus (Lash-around-Retraktion) wickelt sich die Zilie um die Außenseite der Zoospore, wobei die Ziliarmembran mit der Plasmamembran verschmilzt. Auf mit 120 kDa (Kilodalton) Fibronectin[A. 2] beschichteten Hydrogelen erfolgt diese Umschlingung innerhalb einer Sekunde.
- Beim vierten Modus (Retraktion des Ziliarkompartiments) folgt auf die Expansion der Ziliarmembran die Verschmelzung des Ziliarkompartiments mit der Plasmamembran.
- Beim fünften Modus (vesikuläre Retraktion) entsteht vor der Internalisierung eine Ausbuchtung der Axonemschleife innerhalb der Ziliarmembran.
Nachdem die Zilie zurückgezogen wurde, keimt die Zyste und bildet einen Keimschlauch. Der Keimschlauch wird dann erweitert und bildet das Rhizoidalsystem. Schließlich entwickelt sich die Zyste zu einem Sporangium als reproduktive Struktur, und die Mitose beginnt. Nach fünf- bis achtmaliger synchroner Mitose bilden sich im Sporangium 32 bis 256 Zoosporen. Die Ziliogenese (Wiederbildung von Zilien) findet wahrscheinlich vor der Zellularisierung statt. Nach der Zellularisierung entweichen die Zoosporen unter günstigen Umweltbedingungen aus dem Sporangium.[5]
Das Timing des Zellzyklus wurde mit Hilfe von einer Linie von „S. punctatus“, die H2B-TdTomato unter Kontrolle des H2B-Promotors exprimiert, unter dem Mikroskop quantifiziert. Das Zurückziehen der Zilie und der Beginn der Zystenbildung erfolgen innerhalb einer Stunde. Der Keimschlauch erscheint innerhalb von ein bis drei Stunden. Die erste Mitose findet innerhalb von acht bis zwölf Stunden statt. Innerhalb von dreißig Stunden wurden fünf bis acht synchrone Mitosen abgeschlossen. Der durchschnittliche Zellzyklus dauerte etwa 150 Minuten. Jede Kernteilung war dabei innerhalb einer Minute abgeschlossen.[5]
Mitochondriales 5’-tRNA-Editing
S. punctatus zeichnet sich durch ein 5′-tRNA-Editing in den Mitochondrien aus. Die ist eine seltene Variante des RNA-Editing, die zuvor nur bei der Amoebozoa-Art Acanthamoeba castellanii und den Chytridiomycetes-Arten Harpochytrium sp. 94,[20] Harpochytrium sp. 105,[21] Monoblepharella sp. 15[22] und Hyaloraphidium curvatum[23] vorkommt.[24][25] Das mitochondriale Genom (Mitogenom, mtDNA) von S. punctatus kodiert für acht tRNAs, die Lysin-, Asparagin-, Tryptophan-, Methionin-, Tyrosin-, Glutamin-, Prolin- und Leucin-Codons erkennen. Die letztere, tRNALeu, erkennt das UAG-Codon als Leucin statt als Stopp-Codon.[24]
Die tRNAs bilden Sekundärstrukturen, die sich aus helikalen Stämmen (Haarnadelstrukturen) zusammensetzen. Wie von der mtDNA vorhergesagt, finden sich Fehlpaarungen in den ersten drei Nukleotiden der acht tRNA-Akzeptorstämme. Die Sequenzierung der reifen mitochondrialen tRNAs ergab den Ersatz von Pyrimidinen oder Purinen durch Purine (A zu G, U zu G, U zu A und C zu A), die die Basenpaarung wiederherstellen. Die Änderungsstellen sind immer auf die ersten drei Positionen beschränkt.[24][26]
Das mitochondriale 5'-tRNA-Editing von S. punctatus wurde in vitro bestätigt. Unter Verwendung mitochondrialer Extrakte werden die 5'-Fehlpaarungen synthetischer tRNA-Transkripte entfernt und Nukleotide in 3'-5'-Richtung eingebaut, indem die 3'-tRNA-Sequenz als Vorlage verwendet wird. Die Muster des mitochondrialen 5'-tRNA-Editing ähneln denen, die in Acanthamoeba castellanii gefunden wurden.[27]
Phytohormon-Rezeptor-Homologe
Die Rezeptoren für Ethylen und Cytokinin in Pflanzen sind Histidinkinasen.[28] In Pilzen sind Histidinkinasen hybrid aufgrund der Fusion von Histidinkinase bzw. Histidinkinase-ähnlichen katalytischen Domänen von ATPasen (sog. HK/HATPase-Domänen) mit der Empfängerdomäne. Ethylen- und Cytokinin-Rezeptor-Homologe finden sich auch in mehreren Pilzgattungen mit und ohne Flagellen, darunter Spizellomyces. Im Allgemeinen sind diese beiden Phytohormone Signalmoleküle bei biotischen Interaktionen zwischen Pflanzen; bei den sich früh diversifizierenden Pilzen spielen sie möglicherweise eine wichtige Rolle bei der Besiedlung des Landes.[4]
Retinale und Opsine
Grundsätzlich lassen sich zwei Typen von Opsinen unterscheiden:[29][30]
- Opsine des Typs 1 werden von Prokaryoten (Bacteriorhodopsin und Halorhodopsin[31] bei Archaeen) und einigen Algen (Channelrhodopsinen) und Pilzen verwendet.[32]
- Opsine des Typs 2 werden von Tieren genutzt.[29] Opsine dieses Typs gehören zur als Klasse A bezeichneten Proteinfamilie G-Protein-gekoppelten Rezeptoren.[33]
Beide Typen sind Rezeptoren mit sieben Transmembranen und werden durch die kovalente Bindung von Retinal als Chromophor zu Licht wahrnehmenden Photorezeptoren. Sie sind jedoch auf Sequenzebene nicht miteinander verwandt. Die Tatsache, dass sie beide ein Retinal verwenden, ist das Ergebnis einer konvergenten Evolution.[34][35]
Bei Pilzen wie Blastocladiella emersonii (Blastocladiales[36]), einem begeißelten, ebenfalls früh (im Stammbaum) divergierenden Pilz, werden Opsine vom Typ 1 für die Phototaxis verwendet.[37] Bei S. punctatus wurden jedoch keine Opsine vom Typ 1 gefunden,[38] dafür jedoch ein mutmaßliches Opsin vom Typ 2. Dieses hat mit anderen G-Protein-gekoppelten Rezeptoren eine Reihe von konservierten Motiven und Aminosäuren gemeinsam, darunter das Lysin, das dem Residuum 296 im Rinderrhodopsin entspricht[39] (dieses ist für die Netzhautbindung und die Lichtsensorik von Bedeutung[40]). Wie das TM-Score (englisch Template modeling score, auch template-based structure modelling[41]) nahelegt, ist es auch strukturell den tierischen Typ-2-Opsinen ähnlich. Zumindest rechnerisch kann es Retinal als Chromophor binden; allerdings bindet es bevorzugt 9-cis-Retinal,[39][42] im Gegensatz zu den meisten klassischen tierischen Typ-2-Opsinen, wie etwa dem Rinderrhodopsin, das im dunklen Zustand an das 11-cis-Retinal bindet[43][44][45][46][47] Die biologische Funktion des Opsins von S. punctatus ist noch unbekannt (Stand 2017).[39] Es ist auch noch nicht klar, ob es sich tatsächlich um ein Opsin vom Typ 2 handelt, da es in der umfassenden Opsin-Phylogenie von Gühmann et al. (2022) fehlt.[48] Wenn es sich tatsächlich um einen Photorezeptor handeln sollte, dann könnte sich die Lichtempfindlichkeit im Prinzip unabhängig von deer anderer Pilze entwickelt haben.
Fanzor-Endonuklease
Fanzor (Fz) ist ein Protein, das von eukaryotischen Transposons kodiert wird und vermutlich aus TnpB hervorgegangen ist, einem Effektor des prokaryotischen RNA-gesteuerten Systems OMEGA.[49] TnpB gilt auch als mutmaßlicher Vorfahr von Cas12, einer RNA-gesteuerten Endonuklease, die im CRISPR/Cas-System verwendet wird. Dies deutet auf eine Verbindung zwischen Fz, TnpB und Cas12 hin, trotz ihrer unterschiedlichen Rollen und Auftretens teils in prokaryotischen, teils in eukaryotischen Zellen. Die Struktur von Fanzor wurde anhand von S. punctatus ausgiebig untersuchet.[50][51]
Viren
Beu Metagenomik-Untersuchungen von Proben des Tiroler Gossenköllesees in den Jahren 2021 und 2023 wurden Gensequenzen mit Bezügen zu Polintons, Polinton-artigen Viren (englisch polinton-like viruses, PLVs; wissenschaftlich Phylum Preplasmiviricota) und Virophagen gefunden. Die Genome integrierten sich teilweise in die der Wirte, zu denen u. a. auch S. punctatus gehört.[52][53]
Systematik
Gattung: Spizellomyces D.J.S. Barr, 1980[54][2]
- Spezies: Spizellomyces acuminatus (D.J.S. Barr) D.J.S. Barr, 1984
- Spezies Spizellomyces dolichospermus D.J.S. Barr, 1984
- Spezies Spizellomyces kniepii A. Gaertn. ex D.J.S. Barr, 1984
- Spezies Spizellomyces lactosolyticus D.J.S. Barr, 1984
- Spezies Spizellomyces ‚palustris‘ A. Gaertn. ex D.J.S. Barr, 1984, nom. inval.
- Spezies Spizellomyces plurigibbosus (D.J.S. Barr) D.J.S. Barr, 1984
- Spezies: Spizellomyces punctatus (W.J. Koch) D.J.S. Barr, 1980[1]
- :Basionym: Phlyctochytrium punctatum W.J. Koch, 1957[1][7]
Anmerkungen
- ↑ englisch: severing, reeling in retraction, lash-around retraction, ciliary compartment loss retraction, and vesicular retraction. Im Einzelnen:
- ↑ Die Originalquelle (Vernard et al. 2020) nennt hier 120 kPa. kPa steht aber für Kilopascal. Offensichtlich handelt es sich um einen Druckfehler, und es ist stattdessen kDa (Kilodalton, Atomare Masseneinheit) Fibronectin[19]gemeint.
Einzelnachweise
- ↑ a b c d e NCBI Taxonomy Browser: Spizellomyces punctatus (W.J. Koch) D.J.S. Barr, 1980 (spezies) [Phlyctochytrium punctatum W.J. Koch, 1957].
- ↑ a b Donald J. S. Barr: An outline for the reclassification of the Chytridiales, and for a new order, the Spizellomycetales. In: Canadian Journal of Botany, Band 58, Nr. 22, November 1980, S. 2380-2394; doi:10.1139/b80-276, ResearchGate, Epub Januar 2011.
- ↑ a b Carsten Russ, B. Franz Lang, Zehua Chen, Sharvari Gujja, Terrance Shea, Qiandong Zeng, Sarah Young, Christina A. Cuomo, Chad Nusbaum: Genome Sequence of Spizellomyces punctatus. In: Genome Announcements, Band 4, Nr. 4, August 2016; doi:10.1128/genomeA.00849-16, PMID 27540072, PMC 4991717 (freier Volltext) (englisch).
- ↑ a b Anaïs Hérivaux, Thomas Dugé de Bernonville, Christophe Roux, Marc Clastre, Vincent Courdavault, Amandine Gastebois, Jean-Philippe Bouchara, Timothy Y. James, Jean-Paul Latgé, Francis Martin, Nicolas Papon: The Identification of Phytohormone Receptor Homologs in Early Diverging Fungi Suggests a Role for Plant Sensing in Land Colonization by Fungi. In: mBio. 8. Jahrgang, Nr. 1, Januar 2017, doi:10.1128/mBio.01739-16, PMID 28143977, PMC 5285503 (freier Volltext) – (englisch).
- ↑ a b c d e f Edgar M. Medina, Kristyn A. Robinson, Kimberly Bellingham-Johnstun, Giuseppe Ianiri, Caroline Laplante, Lillian K. Fritz-Laylin, Nicolas E. Buchler: Genetic transformation of Spizellomyces punctatus, a resource for studying chytrid biology and evolutionary cell biology. In: eLife, Band 9, Mai 2020, S. e52741; doi:10.7554/eLife.52741, PMID 32392127, PMC 7213984 (freier Volltext) (englisch).
- ↑ Matthew C. Fisher, Trenton W. J. Garner: Chytrid fungi and global amphibian declines. In: Nature Reviews. Microbiology. 18. Jahrgang, Nr. 6, Juni 2020, S. 332–343, doi:10.1038/s41579-020-0335-x, PMID 32099078 (englisch).
- ↑ a b William J. Koch: Two new chytrids in pure culture, Phlyctochytrium punctatum and Phlyctochytrium irregulare. In: Journal of the Elisha Mitchell Scientific Society, Band 73, Nr. 1, Mai 1957, S. 108–122, JSTOR:24333923 (englisch).
- ↑ a b Iñaki Ruiz-Trillo, Gertraud Burger, Peter W. H. Holland, Nicole King, B. Franz Lang, Andrew J. Roger, Michael W. Gray: The origins of multicellularity: a multi-taxon genome initiative. In: Trends in Genetics. 23. Jahrgang, Nr. 3, März 2007, S. 113–118, doi:10.1016/j.tig.2007.01.005, PMID 17275133 (englisch).
- ↑ a b NCBI Nucleotide: Spizellomyces punctatus DAOM BR117 GenBank: ACOE00000000 (master record for whole genome shotgun sequencing project). Details: txid109760[Organism:exp] AND DAOM BR117 Spizellomyces punctatus DAOM BR117 …, BioProject Spizellomyces punctatus DAOM BR117 Accession: PRJNA37881.
- ↑ Adriana Gallego: Nourseothricin Overview. Auf: Gold Biotechnology (GoldBio.com).
- ↑ tdTomato. Auf: FPbase (fluorescent protein database, fpbase.org).
- ↑ mClover3. Auf: FPbase (fluorescent protein database, fpbase.org).
- ↑ mCitrine. Auf: FPbase (fluorescent protein database, fpbase.org).
- ↑ mCerulean3. Auf: FPbase (fluorescent protein database, fpbase.org).
- ↑ Synchronisation. Lexikon der Biologie. Auf spektrum.de.
- ↑ Andrew J. M. Swafford, Shane P. Hussey, Lillian K. Fritz-Laylin: High-efficiency electroporation of chytrid fungi. In: Scientific Reports. 10. Jahrgang, Nr. 1, 15. September 2020, S. 15145, doi:10.1038/s41598-020-71618-2, PMID 32934254, PMC 7493940 (freier Volltext), bibcode:2020NatSR..1015145S (englisch).
- ↑ William J. Koch: Studies of the Motile Cells of Chytrids. V. Flagellar Retraction in Posteriorly Uniflagellate Fungi. In: American Journal of Botany. 55. Jahrgang, Nr. 7, 1. August 1968, ISSN 1537-2197, S. 841–859, doi:10.1002/j.1537-2197.1968.tb07442.x (englisch).
- ↑ Claire M. Venard, Krishna Kumar Vasudevan, Tim Stearns: Cilium axoneme internalization and degradation in chytrid fungi. In: Cytoskeleton. 77. Jahrgang, Nr. 10, 26. Oktober 2020, S. 365–378, doi:10.1002/cm.21637, PMID 33103844, PMC 7944584 (freier Volltext) – (englisch).
- ↑ Fibronectin 120 kDa α Chymotryptic Fragment (Cell Attachment region), Human purified. Auf: Merck (sigmaaldrich.com).
- ↑ NCBI Taxonomy Browser: Harpochytrium sp. JEL94, equivalent: Harpochytrium sp. 94 (species), Nucleotide: AY182005.
- ↑
NCBI Taxonomy Browser: Harpochytrium sp. JEL105, equivalent: Harpochytrium sp. 105 (species), Nucleotide: AY182006.
Die bei Laforest et al. (2004) angegebene Zugriffsnummer AY1820006 wurde gem. NCBI zu AY182006 korrigiert. - ↑
NCBI Taxonomy Browser: Monoblepharella sp. JEL15, equivalent: Monoblepharella sp. 15 (species), Nucleotide: AY182007.
Die bei Laforest et al. (2004) angegebene Zugriffsnummer AY1820007 wurde gem. NCBI zu AY182007 korrigiert. - ↑ NCBI Taxonomy Browser: Hyaloraphidium curvatum Korshikov, 1931 (species), Nucleotide: NC_003048. Die bei Laforest et al. (2004) angegebene Zugriffsnummer NC003048 wurde gem. NCBI zu NC_003048 korrigiert.
- ↑ a b c Marie-Josée Laforest, Charles E. Bullerwell, Lise Forget, B. Franz Lang: Origin, evolution, and mechanism of 5' tRNA editing in chytridiomycete fungi. In: RNA. 10. Jahrgang, Nr. 8, August 2004, S. 1191–1199, PMID 15247432, PMC 1370609 (freier Volltext) – (englisch, oup.com).
- ↑ Charles E. Bullerwell, B. Franz Lang: Fungal evolution: the case of the vanishing mitochondrion. In: Current Opinion in Microbiology. 8. Jahrgang, Nr. 4, August 2005, S. 362–369, doi:10.1016/j.mib.2005.06.009, PMID 15993645 (englisch).
- ↑ Marie-Josée Laforest, Ingeborg Roewer, B. Franz Lang: Mitochondrial tRNAs in the lower fungus Spizellomyces punctatus: tRNA editing and UAG 'stop' codons recognized as leucine. In: Nucleic Acids Research, Band 25, Nr. 3, Februar 1997, S. 626–632; doi:10.1093/nar/25.3.626, PMID 9016605, PMC 146481 (freier Volltext) (englisch).
- ↑ Charles E. Bullerwell, Michael W. Gray: In Vitro Characterization of a tRNA Editing Activity in the Mitochondria of Spizellomyces punctatus, a Chytridiomycete Fungus. In: The Journal of Biological Chemistry, Band 280, Nr. 4, Januar 2005, S. 2463–2470; doi:10.1074/jbc.M411273200, PMID 15546859 (englisch).
- ↑ Baptiste Bidon, Samar Kabbara, Vincent Courdavault, Gaélle Glévarec, Audrey Oudin, François Héricourt, Sabine Carpin, Lukáš Spíchal, Brad M. Binder, J. Mark Cock, Nicolas Papon: Cytokinin and Ethylene Cell Signaling Pathways from Prokaryotes to Eukaryotes. In: MDPI: Cells, Band 9, Nr. 11, November 2020, S. 2526; doi:10.3390/cells9112526, PMID 33238457, PMC 7700396 (freier Volltext) (englisch).
- ↑ a b David C. Plachetzki, Caitlin R. Fong, Todd H. Oakley: The evolution of phototransduction from an ancestral cyclic nucleotide gated pathway. In: Proceedings of the Royal Society B: Biological Sciences. 277. Jahrgang, Nr. 1690, 7. Juli 2010, S. 1963–1969, doi:10.1098/rspb.2009.1797, PMID 20219739, PMC 2880087 (freier Volltext) – (englisch).
- ↑ Russell D. Fernald: Casting a Genetic Light on the Evolution of Eyes. In: Science. 313. Jahrgang, Nr. 5795, 29. September 2006, S. 1914–1918, doi:10.1126/science.1127889, PMID 17008522, bibcode:2006Sci...313.1914F (englisch).
- ↑ Halorhodopsin. Lexikon der Biologie, spektrum.de.
- ↑ Stephen A. Waschuk, Arandi G. Bezerra Jr., Lichi Shi, Leonid S. Brown: Leptosphaeria rhodopsin: bacteriorhodopsin-like proton pump from a eukaryote. In: Proceedings of the National Academy of Sciences of the United States of America, Band 102, Nr. 19, Mai 2005, S. 6879–6883, bibcode:2005PNAS..102.6879W; doi:10.1073/pnas.0409659102, PMID 15860584, PMC 1100770 (freier Volltext) (englisch)
- ↑ Vsevolod Katritch, Vadim Cherezov, Raymond C. Stevens: Structure-function of the G protein-coupled receptor superfamily. In: Annual Review of Pharmacology and Toxicology. 53. Jahrgang, Nr. 1, 6. Januar 2013, S. 531–556, doi:10.1146/annurev-pharmtox-032112-135923, PMID 23140243, PMC 3540149 (freier Volltext) – (englisch).
- ↑ John B. C. Findlay, Darryl J. C. Pappin: The opsin family of proteins. In: The Biochemical Journal. 238. Jahrgang, Nr. 3, 15. September 1986, S. 625–42, doi:10.1042/bj2380625, PMID 2948499, PMC 1147185 (freier Volltext) – (englisch).
- ↑ De-Liang Chen, Guang-yu Wang, Bing Xu, Kun-Sheng Hu: All-trans to 13-cis retinal isomerization in light-adapted bacteriorhodopsin at acidic pH. In: Journal of Photochemistry and Photobiology B: Biology. 66. Jahrgang, Nr. 3, April 2002, S. 188–194, doi:10.1016/S1011-1344(02)00245-2, PMID 11960728 (englisch).
- ↑ NCBI Taxonomy Browser: Blastocladiella emersonii, Details: Blastocladiella emersonii Cantino & Hyatt, 1953 (species).
- ↑ Gabriela Mól Avelar, Talita Glaser, Guy Leonard, Thomas A. Richards, Henning Ulrich, Suely L. Gomes: A Cyclic GMP-Dependent K+ Channel in the Blastocladiomycete Fungus Blastocladiella emersonii. In: Eukaryotic Cell, Band 14, Nr. 9, September 2015, S. 958–963; doi:10.1128/EC.00087-15, PMID 26150416, PMC 4551585 (freier Volltext) (englisch).
- ↑ Luis Javier Galindo, David S. Milner, Suely Lopes Gomes, Thomas A. Richards: A light-sensing system in the common ancestor of the fungi. In: Current Biology. 32. Jahrgang, Nr. 14, Juli 2022, S. 3146–3153.e3, doi:10.1016/j.cub.2022.05.034, PMID 35675809, PMC 9616733 (freier Volltext) – (englisch).
- ↑ a b c Steven R. Ahrendt, Edgar Mauricio Medina, Chia-en A. Chang, Jason E. Stajich: Exploring the binding properties and structural stability of an opsin in the chytrid Spizellomyces punctatus using comparative and molecular modeling. In: PeerJ, Band 5, 27. April 2017, S. e3206; doi:10.7717/peerj.3206, PMID 28462022, PMC 5410147 (freier Volltext) (englisch).
- ↑ Nicole Y. Leung, Dhananjay P. Thakur, Adishthi S. Gurav, Sang Hoon Kim, Antonella Di Pizio, Masha Y. Niv, Craig Montell: Functions of Opsins in Drosophila Taste. In: Current Biology, Band 30, Nr. 8, April 2020, S. 1367–1379.e6; doi:10.1016/j.cub.2020.01.068, PMID 32243853, PMC 7252503 (freier Volltext) (englisch).
- ↑ Stephen Price, Stéphane Tombeur, Alexander Hudson, Nanda Kumar Sathiyamoorthy, Paul Smyth, Anjana Singh, Mara Peccianti, Elisa Baroncelli, Ahmed Essaghir, Ilaria Ferlenghi, Sanjay Kumar Phogat, Gurpreet Singh: TMQuery: a database of precomputed template modeling scores for assessment of protein structural similarity. In: Bioinformatics, Band 38, Nr. 7, März 2022, S. 2062–2063; doi:10.1093/bioinformatics/btac044, Epub 1. Februar 2022.
- ↑ 9-cis-Retinal. Auf: Merck (sigmaaldrich.com).
- ↑ George Wald: Carotenoids and the Vitamin A Cycle in Vision. In: Nature. 134. Jahrgang, Nr. 3376, 14. Juli 1934, S. 65, doi:10.1038/134065a0, bibcode:1934Natur.134...65W (englisch).
- ↑ George Wald, Paul K. Brown, Ruth Hubbard, William Oroshnik: Hindered cis Isomers of Vitamin a and Retinene: The Structure of the neo-b Isomer. In: Proceedings of the National Academy of Sciences, Band 41, Nr. 7, 15. Juli 1955, S. 438–451, bibcode:1955PNAS...41..438W; doi:10.1073/pnas.41.7.438, PMID 16589696, PMC 528115 (freier Volltext) (englisch).
- ↑ Paul K. Brown, George Wald: The Neo-b Isomer of Vitamin A and Retinene. In: The Journal of Biological Chemistry. 222. Jahrgang, Nr. 2, Oktober 1956, S. 865–877, doi:10.1016/S0021-9258(20)89944-X, PMID 13367054 (englisch).
- ↑ William Oroshnik: The Synthesis and Configuration of neo-b Vitamin A and Neoretinene b. In: Journal of the American Chemical Society. 78. Jahrgang, Nr. 11, Juni 1956, S. 2651–2652, doi:10.1021/ja01592a095 (englisch).
- ↑ William Oroshnik, Paul K. Brown, Ruth Hubbard, George Wald: Hindered cis Isomers of Vitamin A and Retinene: The Structure of the neo-b Isomer. In: Proceedings of the National Academy of Sciences, Band 42, Nr. 9, September 1956, S. 578–580; doi:10.1073/pnas.42.9.578, PMID 16589909, PMC 534254 (freier Volltext) (englisch).
- ↑ Martin Gühmann, Megan L. Porter, Michael J. Bok: The Gluopsins: Opsins without the Retinal Binding Lysine. In: Cells. 11. Jahrgang, Nr. 15, 6. August 2022, S. 2441, doi:10.3390/cells11152441, PMID 35954284, PMC 9368030 (freier Volltext) – (englisch).
- ↑ Han Altae-Tran, Soumya Kannan, F. Esra Demircioglu, Rachel Oshiro, Suchita P. Nety, Luke J. McKay, Mensur Dlakić, William P. Inskeep, Kira S. Makarova, Rhiannon K. Macrae, Eugene V. Koonin, Feng Zhang: The widespread IS200/IS605 transposon family encodes diverse programmable RNA-guided endonucleases. In: Science, Band 374, Nr. 6563, 9. September 2021, S. 57–65; doi:10.1126/science.abj6856.
- ↑
Makoto Saito: Fanzor is a eukaryotic programmable RNA-guided endonuclease. In: Nature. 28. Juni 2023, doi:10.1038/s41586-023-06356-2, PMID 37380027 (englisch). Dazu:
- Nadja Podbregar: Neue Genschere entdeckt. In: wissenschaft.de. 13. Juli 2023, abgerufen am 20. Juli 2023.
- Theo Dingermann: Fanzor statt CRISPR/Cas: Erste Genschere aus Eukaryoten entdeckt. In: pharmazeutische-zeitung.de. 5. Juli 2023, abgerufen am 20. Juli 2023.
- Leah Eisenstadt: Researchers uncover a new CRISPR-like system in animals that can edit the human genome. In: news.mit.edu. 28. Juni 2023, abgerufen am 20. Juli 2023 (englisch).
- ↑ W. Bao, J. Jurka: Homologues of bacterial TnpB_IS605 are widespread in diverse eukaryotic transposable elements. In: Mobile DNA. Band 4, Nr. 1, April 2013, S. 12; doi:10.1186/1759-8753-4-12, PMID 23548000, PMC 3627910 (freier Volltext).
- ↑
Christopher M. Bellas, Ruben Sommaruga: Polinton-like viruses are abundant in aquatic ecosystems. In: BMC: Microbiome, Band 9, Nr. 13, 12. Januar 2021; doi:10.1186/s40168-020-00956-0. Dazu
- Korrektur vom 27. Januar 2021; doi:10.1186/s40168-020-00956-0.
- Neue Virengruppe im Süßwasser entdeckt. Pressemitteilung der Universität Innsbruck vom 20. Januar 2021.
- New Group of Viruses Discovered in Freshwater (Biology). Auf: The Uncover Reality (UR) vom 24. Januar 2021 (mit Übersetzungsoption).
- ↑
Christopher Bellas, Thomas Hackl, Marie-Sophie Plakolb, Anna Koslová, Matthias G. Fischer, Ruben Sommaruga: Large-scale invasion of unicellular eukaryotic genomes by integrating DNA viruses. In: PNAS, Band 120, Nr. 16, 10. April 2023, e2300465120; doi:10.1073/pnas.2300465120. Dazu:
- Built Into the Genome of the Microbes – Scientists Uncover Over 30,000 “Hidden” Viruses. Auf: SciTechDaily vom 10. Juni 2023. Quelle: Universität Innsbruck.
- Russell McLendon: Scientists Have Found 30,000 New Viruses Hiding in The DNA of Microbes. Auf: sciencealert vom 26. April 2023.
- Stowaways in the genome: Thousands of unknown viruses hide in the DNA of unicellular organisms. Auf ScienceDaily vom 11. April 2021. Quelle: Universität Innsbruck.
- ↑ NCBI Taxonomy Browser: Spizellomyces, Details: Spizellomyces D.J.S. Barr, 1980 (genus). Graphisch: Spizellomyces, Lifemap NCBI Version.